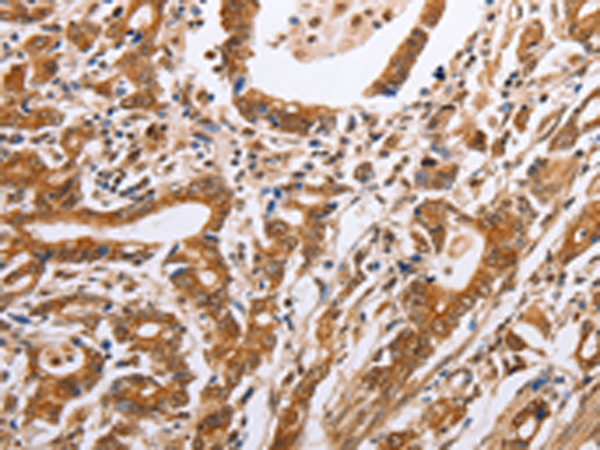
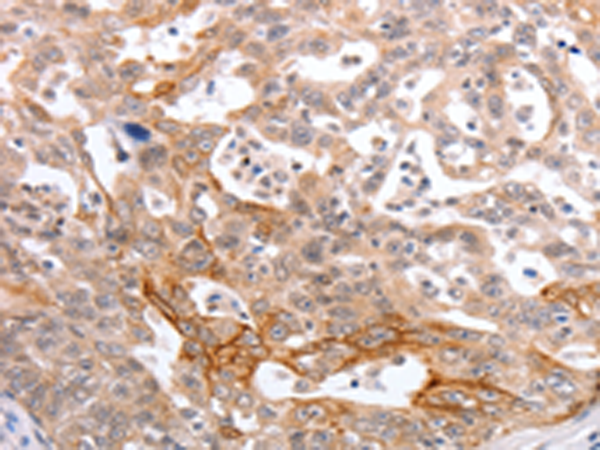
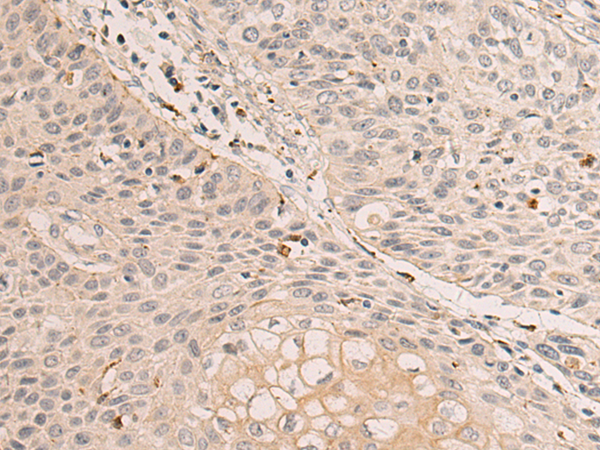

-
分类: 科研抗体货号: P07567别名: S3; P58; RPN3; TSTA2应用: WB,IHC反应种属: Human, Mouse
-
分类: 科研抗体货号: P07545别名: KAPG; PKACg应用: IHC反应种属: Human
-
分类: 科研抗体货号: P07566别名: S14, p31, HIP6, HYPF, Nin1p, Rpn12应用: IHC反应种属: Human, Mouse
-
分类: 科研抗体货号: P07544别名: HIWI, MIWI, PIWI应用: IHC反应种属: Human, Mouse
-
分类: 科研抗体货号: P07563别名: HH13; OV-1; PRL2; HH7-2; PRL-2; PTP4A; HU-PP-1; PTPCAAX2; ptp-IV1a; ptp-IV1b应用: WB,IHC反应种属: Human, Mouse, Rat
-
分类: 科研抗体货号: P07543别名: HIWI2, MIWI2应用: IHC反应种属: Human, Mouse, Rat
-
分类: 科研抗体货号: P07560别名: PRX, p29, AOP2, 1-Cys, NSGPx, aiPLA2应用: WB,IHC反应种属: Human, Mouse, Rat
-
分类: 科研抗体货号: P07540别名: PHB1应用: WB,IHC反应种属: Human, Mouse, Rat
-
分类: 科研抗体货号: P07559别名: PLP; ACR1; B166; PRXV; PMP20; PRDX6; SBBI10; AOEB166应用: IHC反应种属: Human, Mouse, Rat
-
分类: 科研抗体货号: P07539别名: GEP; GP88; PEPI; PGRN; CLN11; PCDGF应用: IHC反应种属: Human

鄂公网安备42018502007531号
鄂公网安备42018502007531号

